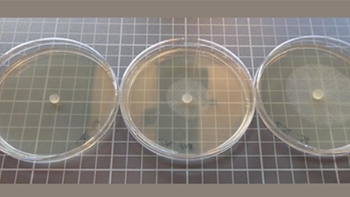
sclerotinia-caracterisation-de-la-sensibiliteau-boscalid-prothioconazole-au-metconazole-ou-a-l-azoxystrobine

La contamination du colza par le sclérotinia se fait par l’intermédiaire des pétales. En conséquence la période de risque débute à partir de la chute des premiers pétales.
Pour décider d’une intervention, il convient :
- d’évaluer le risque sclérotinia,
- d’intervenir si nécessaire à la date du stade optimal G1 (chute des premiers pétales)
Evaluer le risque sclérotinia
Les bulletins de santé du végétal (BSV) alertent sur le niveau régional du risque sclérotinia.
Le niveau de risque parcellaire peut être évaluer a priori selon :
- le nombre de cultures sensibles au sclérotinia dans la rotation culturale,
- les attaques subies lors des années antérieures,
- le temps humide avant la floraison, favorable à la production d’inoculum,
- la densité du couvert et l’enherbement qui, par un maintien d’humidité, favorisent le développement de la maladie.
Reconnaître le stade optimal d’intervention

Intervention
Les solutions fongicides autorisées sont efficaces si elles sont appliquées préventivement au stade G1.
Le choix du fongicide doit tenir compte de l’évolution de la résistance du sclérotinia aux fongicides SDHI (famille chimique du boscalide / Pictor Pro) :
- éviter l’emploi d’un fongicide à base de SDHI seul (Pictor Pro, Haregi)
- limiter la fréquence d’intervention à une application unique de SDHI par campagne.
Pour gérer durablement cette résistance, il est recommandé d’alterner les modes d’action à la parcelle de colza ou d’utiliser un produit associant différents modes d’action d’efficacités équivalentes.
Utiliser un traitement adapté à l’oïdium si nécessaire.
Sclerotinia : caractérisation d'une résistance
Recherche d’une résistance de Sclerotinia par la mise en croissance du champignon sur un milieu de culture contenant un fongicide.
Nous contacter
Adapter l'itinéraire technique du colza pour optimiser l'usage des fongicides
Cette formation s’adresse aux techniciens et agriculteurs qui souhaitent diminuer l'usage des fongicides colza, sans pour autant pénaliser les performances de la culture.
S'inscrire à la formation
Sclérotinia du colza : KIT Pétales
Ce KIT Pétales constitué de 10 boites de Petri permettant de détecter la présence de sclérotinia sur fleurs de colza. Ce kit permet de déterminer le pourcentage de fleurs contaminées en début de floraison.
Acheter
